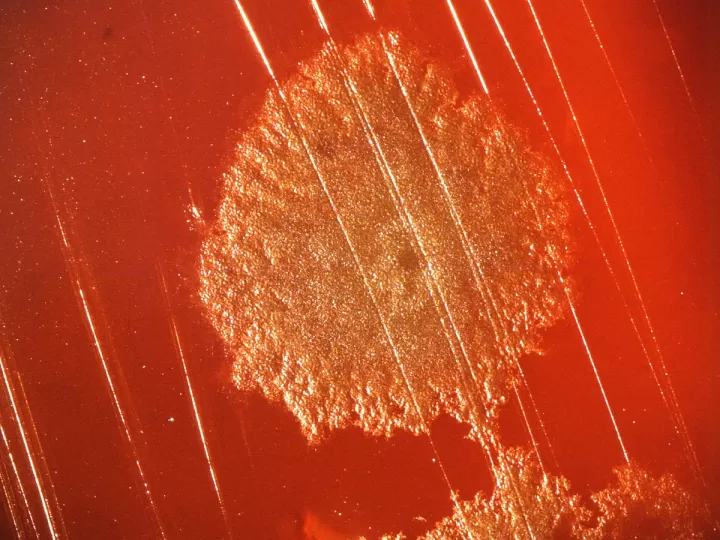
colonia atkinson 620ml

Los beneficios de la lectura y cómo incorporarla en tu rutina diaria
En la actualidad, la tecnología ha tenido un impacto significativo en todos los aspectos de nuestra vida, desde cómo nos comunicamos hasta cómo hacemos nuestras compras. Con el avance de la tecnología, también han surgido nuevas formas de hacer negocios y de promocionar productos y servicios. Una de estas formas es el marketing digital, que se ha convertido en una herramienta esencial para las empresas que desean llegar a su audiencia en un entorno cada vez más digitalizado. En este artículo, exploraremos en qué consiste el marketing digital, sus ventajas y cómo se ha convertido en una tendencia imperante en el mundo empresarial.
La importancia de tener una alimentación saludable para una vida plena y activa
Hoy en día, es común escuchar hablar sobre la importancia de llevar una alimentación saludable para mantener una buena salud. Sin embargo, ¿realmente sabemos qué beneficios aporta a nuestro cuerpo tener una dieta equilibrada y variada?
Una alimentación saludable no solo se trata de tener una figura estética, sino de alimentarnos de forma adecuada para garantizar el correcto funcionamiento de nuestro organismo y prevenir enfermedades. Además, una buena alimentación nos proporciona energía para realizar nuestras actividades diarias y sentirnos activos y vitales.
Para mantener una alimentación saludable es necesario incluir en nuestra dieta una variedad de alimentos de todos los grupos alimenticios como:
Además, es importante tener en cuenta que la forma en que preparamos nuestros alimentos también influye en su valor nutritivo. Optar por técnicas de cocción saludables como asar, hervir o cocer al vapor, en lugar de freír o empanar, puede marcar una gran diferencia en nuestra alimentación.
Una alimentación saludable no solo nos aporta beneficios físicos, sino también mentales. Estar bien alimentados mejora nuestro estado de ánimo y nos ayuda a sentirnos más felices y motivados. Por el contrario, una mala alimentación puede repercutir en nuestra salud mental, provocando cansancio, irritabilidad y alteraciones en el sueño.
No se trata de seguir dietas restrictivas, sino de tomar conciencia sobre la importancia de cuidar nuestra salud a través de una alimentación saludable y disfrutar de la comida de forma consciente y responsable.
Los componentes básicos de una dieta equilibrada
A la hora de llevar una alimentación adecuada, es esencial conocer los componentes básicos de una dieta equilibrada. Estos son los nutrientes fundamentales que nuestro cuerpo necesita para funcionar de manera óptima y mantener una buena salud. A continuación, te explicamos en detalle cada uno de ellos.
Proteínas
Las proteínas son esenciales para la construcción y reparación de tejidos en nuestro cuerpo. Además, juegan un papel importante en la formación de enzimas y hormonas. Se pueden encontrar en alimentos como carnes, pescados, huevos, legumbres y lácteos.
Hidratos de carbono
Los hidratos de carbono son la principal fuente de energía para nuestro organismo. Se dividen en dos tipos: simples y complejos. Los hidratos de carbono simples se encuentran en azúcares y alimentos procesados, mientras que los complejos se encuentran en cereales integrales, frutas y verduras.
Grasas
Las grasas son necesarias para la absorción de vitaminas liposolubles y para una correcta función del sistema nervioso. Sin embargo, es importante consumirlas de manera moderada y elegir fuentes saludables, como aceite de oliva, pescados grasos y frutos secos.
Vitaminas y minerales
Estos nutrientes son esenciales para el buen funcionamiento de nuestro organismo. Las vitaminas son compuestos orgánicos que se encuentran principalmente en frutas y verduras, y los minerales son elementos inorgánicos que se pueden encontrar en alimentos de origen animal y vegetal.
Recuerda que una dieta equilibrada debe incluir todos estos componentes en las proporciones adecuadas. Además, es importante variar los alimentos y no excedernos en el consumo de alimentos procesados y grasas saturadas. Una alimentación saludable es clave para llevar una vida sana y prevenir enfermedades.
Cinco alimentos clave para una nutrición óptima
Una buena alimentación es esencial para mantener una buena salud y prevenir enfermedades. A continuación, te presentamos una lista de cinco alimentos que no pueden faltar en tu dieta si quieres asegurar una nutrición óptima:
Recuerda siempre mantener una dieta equilibrada y variada para obtener todos los nutrientes necesarios para una buena nutrición. Consulta con un profesional de la salud para obtener recomendaciones específicas para tu caso.
Cómo planificar y mantener una dieta balanceada
Una buena alimentación es esencial para llevar una vida saludable y en forma. Sin embargo, con tantos alimentos procesados y opciones poco saludables en el mercado, puede ser un desafío mantener una dieta equilibrada y nutritiva. Aquí te mostramos algunos consejos para planificar y mantener una dieta balanceada en tu día a día.
1. Conoce tus necesidades nutricionales
El primer paso para planificar una dieta balanceada es conocer las necesidades nutricionales de tu cuerpo. La cantidad de calorías, grasas, proteínas, carbohidratos y otros nutrientes que necesitas depende de factores como tu edad, sexo, altura, peso y nivel de actividad física. Puedes consultar con un especialista en nutrición para obtener una evaluación personalizada de tus necesidades.
2. Incluye una variedad de alimentos en tus comidas
Un error común en la planificación de una dieta es limitarse a ciertos alimentos o grupos de alimentos. Para tener una dieta balanceada, es importante incluir una variedad de alimentos de todos los grupos alimenticios, como frutas, verduras, granos enteros, proteínas magras y grasas saludables. Esto asegurará que tu cuerpo reciba todos los nutrientes que necesita para funcionar correctamente.
3. No te saltes las comidas
Es fácil caer en la tentación de saltear comidas cuando tienes poco tiempo o estás tratando de perder peso. Sin embargo, no es una buena idea para mantener una dieta balanceada. Saltarse comidas puede hacer que te sientas cansado, irritable y desencadenar antojos poco saludables. En cambio, planea comidas pequeñas y nutritivas a lo largo del día para mantener tu metabolismo activo y tus niveles de energía estables.
4. Lee las etiquetas de los alimentos
Leer las etiquetas de los alimentos es esencial para saber lo que estás consumiendo. Muchos alimentos procesados y envasados pueden ser altos en sodio, azúcares agregados y grasas trans, que son perjudiciales para la salud. Asegúrate de revisar la información nutricional y los ingredientes antes de comprar un producto y elige opciones más saludables con menos ingredientes procesados.
5. Disfruta de tus comidas y mantente activo
Mantener una dieta balanceada no significa renunciar a tus alimentos favoritos o comer siempre cosas que no te gustan. La clave es encontrar un equilibrio y disfrutar de tus comidas de forma moderada. Además, combinar una alimentación saludable con actividad física regular te ayudará a mantener un peso saludable y sentirte bien tanto por dentro como por fuera.
Siguiendo estos consejos, podrás planificar y mantener una dieta balanceada que te ayudará a sentirte mejor y a llevar una vida más saludable. Recuerda que cada cuerpo es diferente, por lo que siempre es importante consultar con un profesional de la salud para obtener una orientación personalizada y adecuada a tus necesidades.








